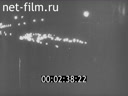
Кадр видео

Киножурнал Тонвохе №428 (1938)

Часть 1
0:06:31
Часть 2
0:07:20Тонвохе №428 (1938)
Часть №1

Германия.
Кадры из хроники 1-й мировой войны.
Мощный взрыв на земле, взметаются тучи пыли.
Ноябрь 1918 года, демонстрации в Берлине, идут солдаты, гражданские лица с оружием.
Лозунги против войны.
Митинг у рейхсканцелярии.
Подписание Версальского договора.
Разрушение военных заводов, укреплений, потопление флота.
Груды металлолома из орудий.
Рейхсвер на учениях с макетами танков и самолетов.
Германия. 5-я годовщина Мюнхенского путча 9 ноября 1933 года.
Ночная демонстрация фашистов с факелами.
Германия.
Восстановление военной мощи в фашистской Германии.
Создание вермахта, маршируют моряки, солдаты на параде.
Заголовки газет.
Новые самолёты, корабли «Шарнхоф», «Принц Евгений».
Военно-морской и воздушный флоты на параде.
Новые виды вооружений: артиллерия, танки.
Военные манёвры.
Австрия.
Насильственное присоединение /аншлюс/ Австрии к Германии.
Немецкие солдаты в Австрии.
Жители Вены приветствуют немецкие войска, марширующие по заснеженному городу.
Германия.
Строительство укреплений Западного вала.
Карта с границами Германии, Голландии, Бельгии, Франции.
Линия вала.
Рабочие на строительных работах.
Солдаты заходят внутрь укрепления, помещения, умывальня, полевая кухня, радиостанция.
Ключевые слова:
Германия, 1938, война 1 мировая, взрывы, демонстрации, солдаты, митинги, Версальский договор, разрушения, учения, Германия, 1938, демонстрации, фашистские празднества, Германия, 1938, моряки, солдаты, парад, ВВС, ВМФ, артиллерия, танки, маневры, Австрия, 1938, солдаты, аншлюс, население, Германия, 1938, строительство, рабочие, солдаты, полевая кухня, оборонительные укрепления
Часть №2




Продолжение.
Вид внутри и снаружи укрепления.
Чехословакия.
Судеты на карте.
Открывается шлагбаум.
Захват Судетской области гитлеровскими войсками.
Прибытие Гитлера на оккупированную территорию Судет, он проезжает в автомобиле, его приветствуют войска.
В городе проходит парад.
Жители приветствуют фюрера.
Германия. 9 ноября в Мюнхене.
Фашистские штандарты, горит вечный огонь на могилах павших фашистов.
Стела и памятник у гробницы, даты: 1923-1938. Знаменитый кабачок.
По улице города парадом идут фашисты, впереди Гитлер, Геринг и их соратники.
Они проходят мимо стел с именами павших, по ходу диктор зачитывает их имена.
Стела с именем Хорста Весселя.
Митинг в зале.
Гитлер, Геринг и другие стоят, вытянув руки.
Возложение венков.
Венки несут по улице, подходят к площади с пантеоном.
Гитлер жмёт руки вдовам погибших фашистов.
Офицер зачитывает список с именами, несут венки.
Стоит Гесс с генералами.
Гитлер спускается с лестницы, поправляет венок, отдаёт честь.
Вечный огонь.
Ключевые слова:
Германия, 1938, укрепления, Чехословакия, 1938, солдаты, Гитлер, парад, Судеты, Германия, 1938, вечный огонь, парад, Гитлер, Геринг, митинги, возложение венков, Гесс, фашистские празднества